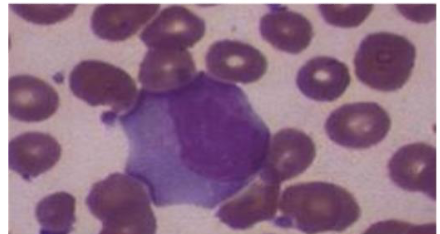

What is it?
Mono is caused by the Epstein-Barr virus (EBV) 85%, also can be caused by cytomegalovirus (CMV), a herpes virus most commonly found in body fluids.
- It is most common in older children and adolescents.
- About half of the people infected with EBV will develop symptoms.
- Mononucleosis is associated with fatigue that can last up to several months. Symptoms are not usually felt until 4–7 weeks after exposure to EBV.
Main Symptoms
- Sore throat and tonsils.
- Swollen lymph glands (nodes) in the neck and, less commonly, the armpits and groin area. (kissing tonsils)
- Jaundice (yellow skin and eyes).
- Enlarged spleen and liver, causing abdominal pain.
- Abdominal pain, Headache.
- Chest pain, Skin rashes.

Flu-Like Symptoms
- Fever and chills (most contagious point)
- Malaise - A general feeling of unwellness
- Nausea, Coughing.
- Loss of appetite and energy
- Muscle soreness/aching
Diagnosis
- Symptoms such as swollen glands in the neck, sore tonsils, exhaustion, and extended lack of energy are easily recognizable as symptoms of mononucleosis.
- Monospot test.
- An increased number of white blood cells or lymphocytes in the smear of blood can indicate the presence of Mononucleosis.
Test Results Interpretation

How is it spread?
- Through direct and indirect contact with the nose and throat secretions of an infected child:
- Kissing
- Sharing anything that children put in their mouths (e.g., toys, sippy cups, food, drinks, soothers)
- Touching something contaminated with an infected person’s saliva.
Incubation Period
Usually 4 – 6 weeks from contact with an infected person.
When is the person contagious?
Unclear, but prolonged. The infected child is most infectious when symptoms are at their peak but may remain infectious for up to a year after illness.
How to prevent spread of the illness to other children?
Child may go to school or child care when they feel well enough to take part in activities. This may take 1 – 2 weeks or longer after symptoms develop.
Carefully dispose of (or clean, if applicable) articles soiled with the nose and throat secretions of an infected child.
Treatment
- There is no specific treatment or therapy for mononucleosis.
- They are also strongly advised to avoid contact sports to reduce the risk of rupturing the enlarged spleen.
- A blow to the abdomen could rupture the spleen, causing severe bleeding and can be life-threatening.
- To relieve the sore throat, patients should drink water, non-citrus fruit juices, and eat bland foods.
- Paracetamol has also been shown to help along with high fluid intake.
- Vitamins and minerals play a role in a healthy immune system and may help to prevent EBV infections and reactivations of the virus.
- Studies show vitamin D may help boost the immune response to the virus.
- High-dose vitamin C therapy has also been shown to help clear EBV infections, which may help prevent reactivation.
- Gargling salt water or mouthwash may also relieve pain. Often mononucleosis is accompanied by a streptococcal infection (known as strep throat), which can be treated with antibiotics.
- Normal function should return after 4–6 weeks; however, it may take up to 2–3 months to fully recover pre-disease activity levels.